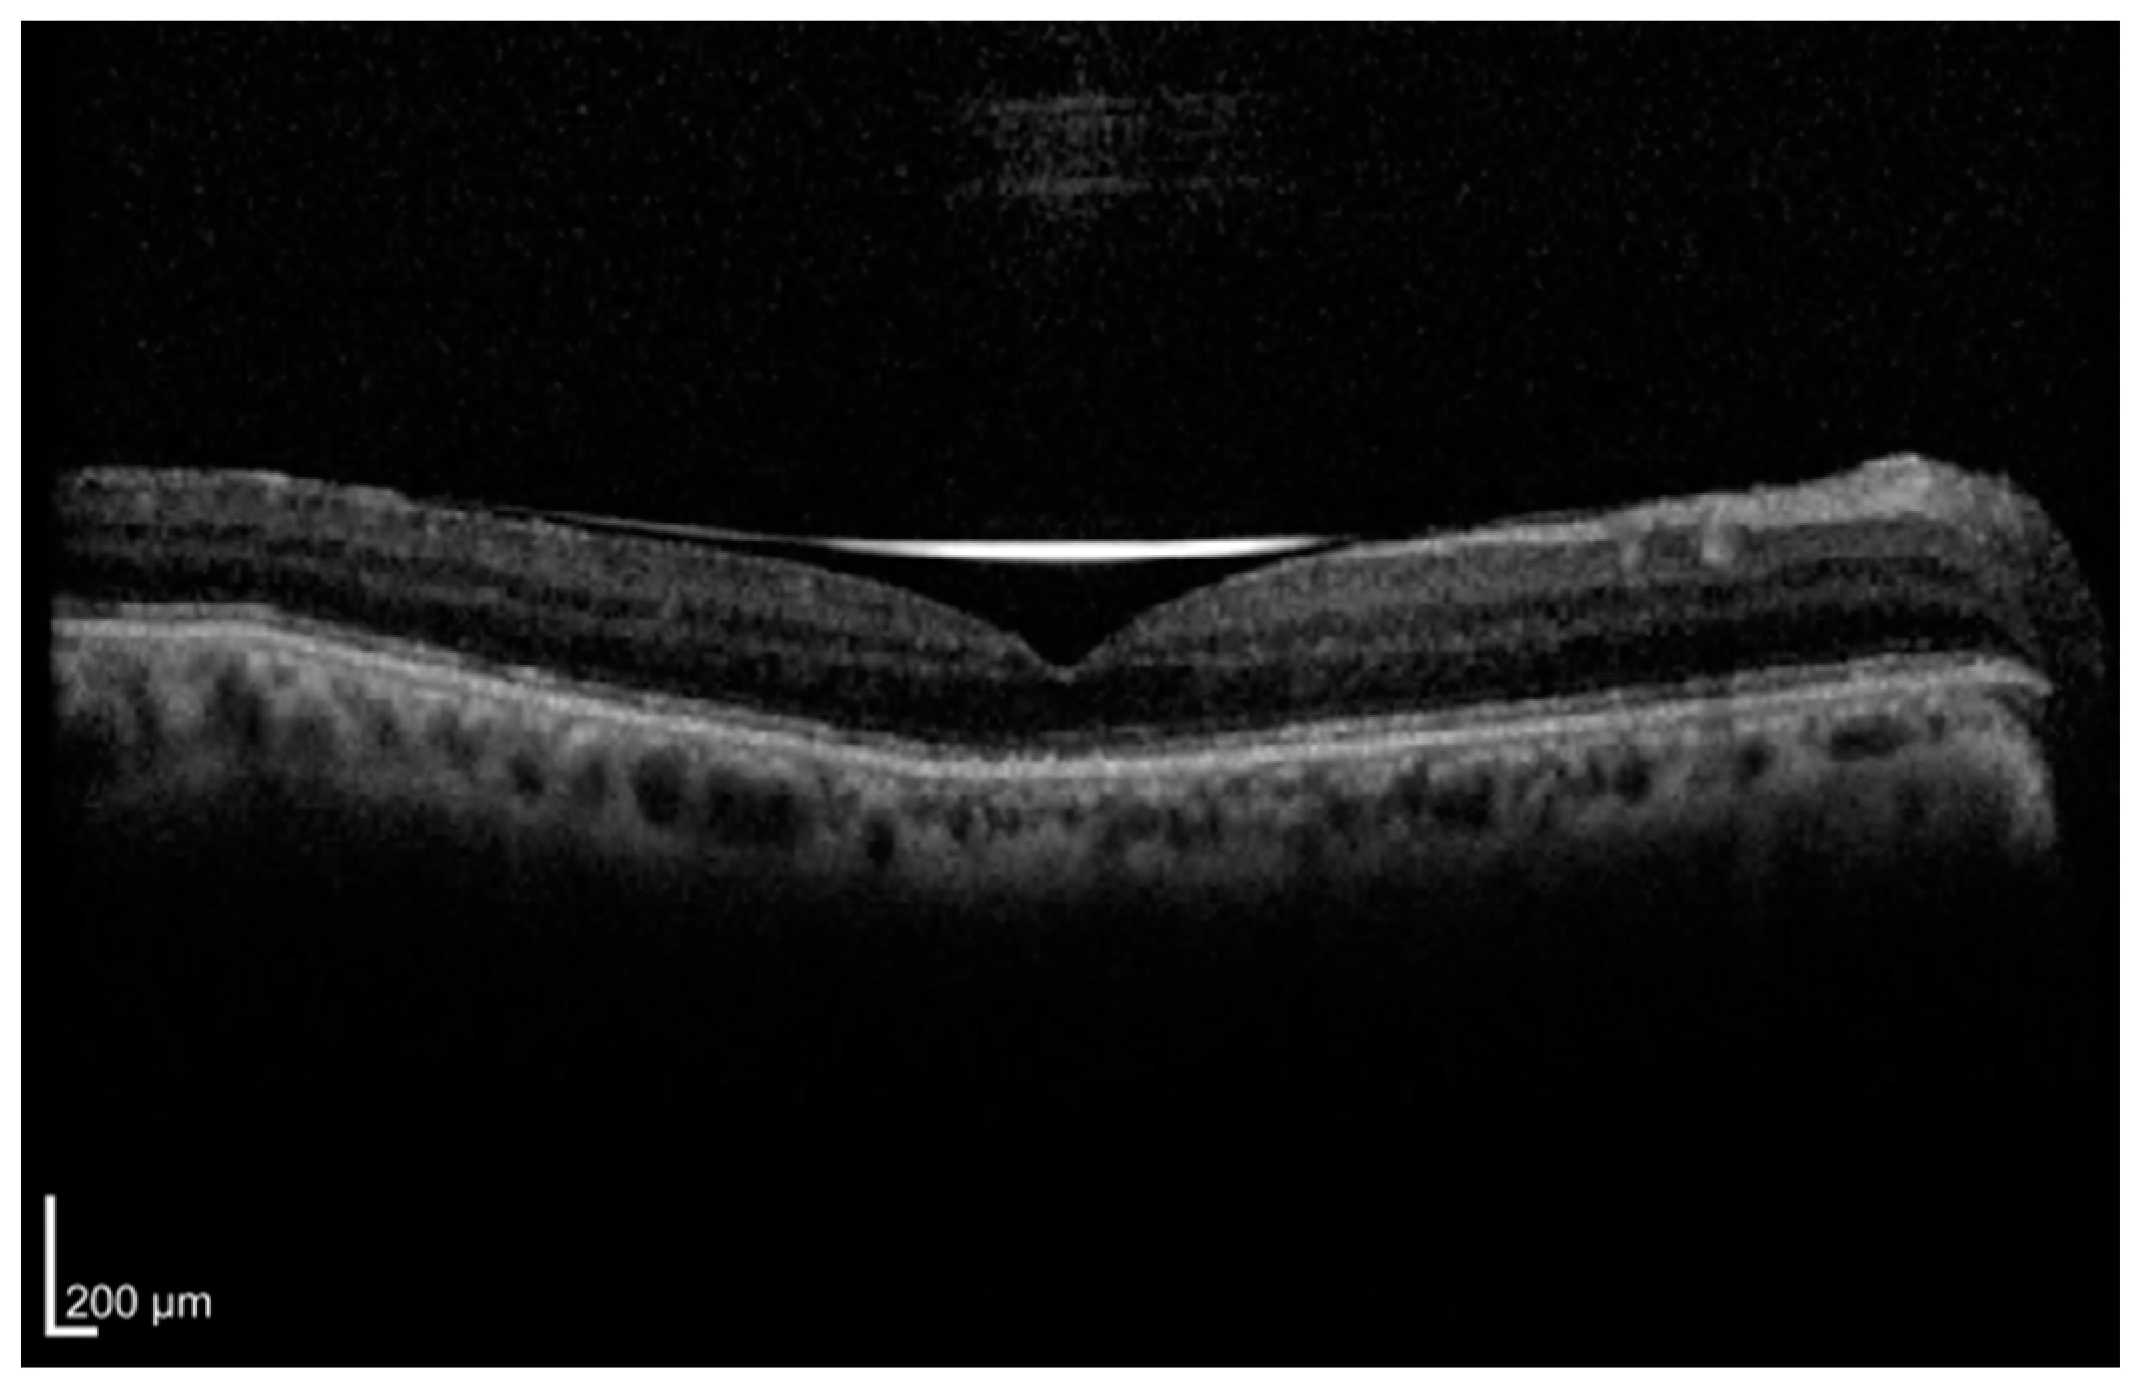
Diagnostics 15 00871 g001

Optical Coherence Tomography in Retinal Detachment: Prognostic Biomarkers, Surgical Planning, and Postoperative Monitoring
Abstract
1. Introduction
2. Methods
2.1. Prognostic OCT Features in Retinal Detachment
2.1.1. Photoreceptor Layer Integrity
2.1.2. Height of Retinal Detachment
2.1.3. Intraretinal Cystic Cavities
2.1.4. Retinal Thickness
2.1.5. Outer Retinal Corrugations
2.1.6. Outer Retinal Undulations
2.1.7. Macular Detachment
2.2. OCT in Surgical Planning
2.2.1. Spectral-Domain OCT and Swept-Source OCT
2.2.2. OCT Angiography
2.2.3. Adaptive Optics OCT
2.2.4. En Face OCT
2.2.5. Artificial Intelligence and Machine Learning
3. Postoperative OCT Monitoring
3.1. Persistent Subretinal Fluid
3.2. Photoreceptor Integrity Recovery
3.3. Cystoid Macular Edema and Epiretinal Membranes
3.4. Demographic and Clinical Characteristics
4. Conclusions
5. Future Directions
Funding
Conflicts of Interest
Abbreviations
| AO-OCT | Adaptive optics optical coherence tomography |
| BCVA | Best-corrected visual acuity |
| CIZ | Cone interdigitation zone |
| CMT | Central macular thickness |
| ELM | External limiting membrane |
| ERD | Exudative retinal detachment |
| FAZ | Foveal avascular zone |
| HRD | Height of retinal detachment |
| ICCs | Intraretinal cystic cavities |
| INL | Inner nuclear layer |
| OCT | Optical coherence tomography |
| OCT-A | Optical coherence tomography angiography |
| ONL | Outer nuclear layer |
| ORCs | Outer retinal corrugations |
| ORUs | Outer retinal undulations |
| PFCL | Perfluorocarbon liquid |
| PR | Posterior retinotomy |
| PRB | Peripheral retinal break |
| RRD | Rhegmatogenous retinal detachment |
| RT | Retinal thickness |
| SD-OCT | Spectral-domain optical coherence tomography |
| SS-OCT | Swept-source optical coherence tomography |
| TRD | Tractional retinal detachment |
| VD | Vessel density |
References
- Mitry, D.; Charteris, D.G.; Fleck, B.W.; Campbell, H.; Singh, J. The epidemiology of rhegmatogenous retinal detachment: Geographical variation and clinical associations. Br. J. Ophthalmol. 2010, 94, 678–684. [Google Scholar] [CrossRef]
- Hakin, K.N.; Lavin, M.J.; Leaver, P.K. Primary vitrectomy for rhegmatogenous retinal detachment. Graefes Arch. Clin. Exp. Ophthalmol. 1993, 231, 344–346. [Google Scholar] [CrossRef]
- Ross, W.H.; Stockl, F.A. Visual recovery after retinal detachment. Curr. Opin. Ophthalmol. 2000, 11, 191–194. [Google Scholar] [CrossRef]
- Salicone, A.; Smiddy, W.E.; Venkatraman, A.; Feuer, W. Visual Recovery after Scleral Buckling Procedure for Retinal Detachment. Ophthalmology 2006, 113, 1734–1742. [Google Scholar] [CrossRef]
- Mendrinos, E.; Dang-Burgener, N.P.; Stangos, A.N.; Sommerhalder, J.; Pournaras, C.J. Primary Vitrectomy without Scleral Buckling for Pseudophakic Rhegmatogenous Retinal Detachment. Am. J. Ophthalmol. 2008, 145, 1063–1070.e1062. [Google Scholar] [CrossRef]
- Delolme, M.P.; Dugas, B.; Nicot, F.; Muselier, A.; Bron, A.M.; Creuzot-Garcher, C. Anatomical and Functional Macular Changes After Rhegmatogenous Retinal De-tachment With Macula Off. Am. J. Ophthalmol. 2012, 153, 128–136. [Google Scholar] [CrossRef]
- Adelman, R.A.; Parnes, A.J.; Sipperley, J.O.; Ducournau, D. Strategy for the Management of Complex Retinal Detachments: The European Vitreo-Retinal Society Retinal Detachment Study Report 2. Ophthalmology 2013, 120, 1809–1813. [Google Scholar] [CrossRef]
- Borowicz, D.; Nowomiejska, K.; Nowakowska, D.; Brzozowska, A.; Toro, M.D.; Avitabile, T.; Jünemann, A.G.; Rejdak, R. Functional and morphological results of treatment of macula-on and macula-off rhegmatogenous retinal detachment with pars plana vitrectomy and sulfur hexafluoride gas tamponade. BMC Oph-Thalmology 2019, 19, 118. [Google Scholar] [CrossRef]
- Mitry, D.; Fleck, B.W.; Wright, A.F.; Campbell, H.; Charteris, D.G. Pathogenesis of rhegmatogenous retinal detachment: Predisposing anatomy and cell biology. Retina 2010, 30, 1561–1572. [Google Scholar] [CrossRef]
- Gharbiya, M.; Grandinetti, F.; Scavella, V.; Cecere, M.; Esposito, M.; Segnalini, A.; Gabrieli, C.B. Correlation between spectral-domain optical coherence tomography findings and visual outcome after primary rhegmatogenous retinal detachment repair. Retina 2012, 32, 43–53. [Google Scholar] [CrossRef]
- Kobayashi, M.; Iwase, T.; Yamamoto, K.; Ra, E.; Murotani, K.; Matsui, S.; Terasaki, H. Association Between Photoreceptor Regeneration and Visual Acuity Following Surgery for Rhegmatogenous Retinal Detachment. Invest. Ophthalmol. Vis. Sci. 2016, 57, 889–898. [Google Scholar] [CrossRef]
- Abraham, J.R.; Srivastava, S.K.; Reese, J.L.; Ehlers, J.P. Intraoperative OCT Features and Postoperative Ellipsoid Mapping in Primary Macula-Involving Retinal Detachments from the PIONEER Study. Ophthalmol. Retin. 2019, 3, 252–257. [Google Scholar]
- Noda, H.; Kimura, S.; Morizane, Y.; Toshima, S.; Hosokawa, M.M.; Shiode, Y.; Doi, S.; Takahashi, K.; Hosogi, M.; Fujiwara, A.; et al. Relationship between preoperative foveal microstructure and visual acuity in macula-off rhegmatogenous retinal detachment: Imaging Analysis by Swept Source Optical Coherence Tomography. Retina 2020, 40, 1873–1880. [Google Scholar]
- Guan, I.; Gupta, M.P.; Papakostas, T.; Wu, A.; Nadelmann, J.; D’Amico, D.J.; Kiss, S.; Orlin, A. Role of optical coherence tomography for predicting post-oper-ative visual outcomes after repair of macula-off rhegmatogenous retinal detachment. Retina 2021, 41, 2017–2025. [Google Scholar]
- Sridhar, J.; Flynn, H.W.; Fisher, Y., Jr. Inner segment ellipsoid layer restoration after macula-off rhegmatogenous retinal de-tachment. Ophthalmic Surg. Lasers Imaging Retin. 2015, 46, 103–106. [Google Scholar]
- Kang, H.M.; Lee, S.C.; Lee, C.S. Association of Spectral-Domain Optical Coherence Tomography Findings with Visual Out-come of Macula-Off Rhegmatogenous Retinal Detachment Surgery. Ophthalmologica 2015, 234, 83–90. [Google Scholar] [CrossRef]
- Yeo, Y.D.; Kim, Y.C. Significance of outer retinal undulation on preoperative optical coherence tomography in rhegma-togenous retinal detachment. Sci. Rep. 2020, 10, 15747. [Google Scholar]
- Figueiredo, N.; Sarraf, D.; Gunnemann, F.; Sadda, S.R.; Bansal, A.; Berger, A.R.; Wong, D.T.; Kohly, R.P.; Kertes, P.J.; Hillier, R.J.; et al. Longitudinal Assessment of Ellipsoid Zone Recovery Using En Face Optical Coherence Tomography After Retinal Detachment Repair. Am. J. Ophthalmol. 2022, 236, 212–220. [Google Scholar] [CrossRef]
- Bansal, A.; Hamli, H.; Lee, W.W.; Sarraf, D.; Sadda, S.; Berger, A.R.; Wong, D.T.; Kertes, P.J.; Kohly, R.P.; Hillier, R.J.; et al. En Face OCT in Diagnosis of Persistent Subretinal Fluid and Outer Retinal Folds after Rhegmatogenous Retinal Detachment Repair. Ophthalmol. Retina 2023, 7, 496–502. [Google Scholar]
- Francisconi, C.L.M.; Kim, D.T.; Juncal, V.; Qian, J.; Brosh, K.; Wong, D.; Giavedoni, L.; Berger, A.; Altomare, F.; Muni, R. Foveal Avascular Zone Area Analysis Using OCT Angiography After Pneumatic Retinopexy for Macula-Off Rhegmatogenous Retinal Detachment Repair. J. Vitr. Dis. 2019, 3, 297–303. [Google Scholar] [CrossRef]
- Park, D.H.; Choi, K.S.; Sun, H.J.; Lee, S.J. Factors associated with visual outcome after macula-off rheg-ma-togenous retinal detachment surgery. Retina 2018, 38, 137–147. [Google Scholar]
- Ooto, S.; Hangai, M.; Sakamoto, A.; Tsujikawa, A.; Yamashiro, K.; Ojima, Y.; Yamada, Y.; Mukai, H.; Oshima, S.; Inoue, T.; et al. High-resolution imaging of resolved central serous chorioretinopathy using adaptive optics scanning laser ophthalmoscopy. Ophthalmology 2010, 117, 1800–1809. [Google Scholar]
- Klaas, J.E.; Rechl, P.; Feucht, N.; Siedlecki, J.; Friedrich, J.; Lohmann, C.P.; Maier, M. Functional recovery after macula involving retinal detachment and its correlation with preoperative biomarkers in optical coherence tomography. Graefes Arch. Clin. Exp. Ophthalmol. 2021, 259, 2521–2531. [Google Scholar]
- Zgolli, H.; Mabrouk, S.; Khayrallah, O.; Fekih, O.; Zeghal, I.; Nacef, L. Prognostic factors for visual recovery in idiopathic rhegmatogenous retinal de-tachment: A prospective study of 90 patients. Tunis. Med. 2021, 99, 972–979. [Google Scholar]
- Matsui, A.; Toshida, H.; Honda, R.; Seto, T.; Ohta, T.; Murakami, A. Preoperative and Postoperative Optical Coherence Tomography Findings in Patients with Rhegmatogenous Retinal Detachment Involving the Macular Region. Int. Sch. Res. Not. 2013, 2013, 426867. [Google Scholar]
- Yilmaz, S.; Yalçinbayir, Ö.; Avci, R.; Kaderli, B.; Bülent, O. Contribution of Multifocal Electroretinography and Optical Coherence Tomography in Predicting the Visual Prognosis of Rhegmatogenous Retinal Detachment. Turk. Klin. J. Med. Sci. 2013, 33, 374. [Google Scholar]
- Lecleire-Collet, A.; Muraine, M.; Menard, J.F.; Brasseur, G. Predictive visual outcome after macula-off retinal detachment surgery using optical coherence tomography. Retina 2005, 25, 44–53. [Google Scholar]
- Poulsen, C.D.; Petersen, M.P.; Green, A.; Peto, T.; Grauslund, J. Fundus autofluorescence and spectral domain optical coherence tomography as predictors for long-term functional outcome in rhegmatogenous retinal detachment. Graefes Arch. Clin. Exp. Ophthalmol. 2019, 257, 715–723. [Google Scholar]
- Baumann, C.; Almarzooqi, A.; Johannigmann-Malek, N.; Maier, M.; Kaye, S. Importance of subfoveal fluid height on visual outcome in macula-off retinal detachments. Br. J. Ophthalmol. 2023, 107, 1467. [Google Scholar]
- Angermann, R.; Mosböck, S.; Palme, C.; Ulmer, H.; Rauchegger, T.; Nowosielski, Y.; Bechrakis, N.E.; Zehetner, C. Impact of submacular fluid volume on visual outcome in macula-off rheg-ma-togenous retinal detachment using automated optical coherence tomography volumetric quantification. Clin. Exp. Ophthalmol. 2021, 49, 439–447. [Google Scholar]
- Joe, S.G.; Kim, Y.J.; Chae, J.B.; Yang, S.J.; Lee, J.Y.; Kim, J.G.; Yoon, Y.H. Structural recovery of the detached macula after retinal detachment repair as assessed by optical coherence tomography. Korean J. Ophthalmol. 2013, 27, 178–185. [Google Scholar] [PubMed]
- Hostovsky, A.; Trussart, R.; AlAli, A.; Kertes, P.J.; Eng, K.T. Pre-operative optical coherence tomography findings in macula-off retinal de-tachments and visual outcome. Eye 2021, 35, 3285–3291. [Google Scholar]
- Murtaza, F.; Goud, R.; Belhouari, S.; Eng, K.T.; Mandelcorn, E.D.; da Costa, B.R.; Miranda, R.N.; Felfeli, T. Prognostic Features of Preoperative OCT in Retinal Detachments: A Systematic Review and Meta-analysis. Ophthalmol. Retina 2023, 7, 383–397. [Google Scholar]
- Nair, U.; Sheth, J.U.; Indurkar, A.; Soman, M. Intraretinal Cysts in Macular Hole: A Structure-Function Correlation Based on En Face Imaging. Clin. Ophthalmol. 2021, 15, 2953–2962. [Google Scholar]
- Vinores, S.A. Breakdown of the Blood–Retinal Barrier. Encycl. Eye 2010, 216–222. [Google Scholar] [CrossRef]
- Karacorlu, M.; Sayman Muslubas, I.; Hocaoglu, M.; Arf, S.; Ersoz, M.G. Correlation between morphological changes and functional out-comes of recent-onset macula-off rhegmatogenous retinal detachment: Prognostic factors in rhegmatogenous retinal detachment. Int. Ophthalmol. 2018, 38, 1275–1283. [Google Scholar]
- Hirata, N.; Iwase, T.; Kobayashi, M.; Yamamoto, K.; Ra, E.; Terasaki, H. Correlation between preoperative factors and final visual acuity after successful rhegmatogenous retinal reattachment. Sci. Rep. 2019, 9, 3217. [Google Scholar]
- Iwase, T.; Tomita, R.; Ra, E.; Iwase, C.; Terasaki, H. Investigation of causative factors for unusual shape of macula in eyes with macula-off rhegmatogenous retinal detachment. Jpn. J. Ophthalmol. 2021, 65, 363–371. [Google Scholar]
- Lecleire-Collet, A.; Muraine, M.; Ménard, J.-F.; Brasseur, G. Evaluation of Macular Changes Before and After Successful Retinal De-tachment Surgery Using Stratus-Optical Coherence Tomography. Am. J. Ophthalmol. 2006, 142, 176–179. [Google Scholar]
- Wolfensberger, T.J.; Gonvers, M. Optical coherence tomography in the evaluation of incomplete visual acuity recovery after macula-off retinal detachments. Graefes Arch. Clin. Exp. Ophthalmol. 2002, 240, 85–89. [Google Scholar]
- Nakanishi, H.; Hangai, M.; Unoki, N.; Sakamoto, A.; Tsujikawa, A.; Kita, M.; Yoshimura, N. Spectral-domain optical coherence tomography imaging of the detached macula in rhegmatogenous retinal detachment. Retina 2009, 29, 232–242. [Google Scholar] [PubMed]
- Oquendo, P.L.; Sodhi, G.S.; Naidu, S.C.; Martins Melo, I.; Pecaku, A.; Demian, S.; Belin, P.J.; Lee, W.W.; Christakis, P.G.; Hamli, H.; et al. Optical Coherence Tomography Features in Fovea-Off Exudative vs Rhegma-togenous Retinal Detachment. Am. J. Ophthalmol. 2024, 268, 212–221. [Google Scholar] [PubMed]
- Dalvin, L.A.; Spaide, R.F.; Yannuzzi, L.A.; Freund, K.B.; Pulido, J.S. Hydration folds in rhegmatogenous retinal detachment. Retin. Cases Brief. Rep. 2020, 14, 355–359. [Google Scholar] [PubMed]
- Nagpal, M.; Shakya, K.; Mehrotra, N.; Kothari, K.; Bhatt, K.; Mehta, R.; Shukla, C. Morphometric analysis of fovea with spectral-domain optical coherence to-mography and visual outcome postsurgery for retinal detachment. Indian. J. Ophthalmol. 2014, 62, 846–850. [Google Scholar]
- Dell’omo, R.; Mura, M.; Lesnik Oberstein, S.Y.; Bijl, H.; Tan, H.S. Early simultaneous fundus autofluorescence and optical coherence tomography features after pars plana vitrectomy for primary rhegma-togenous retinal detachment. Retina 2012, 32, 719–728. [Google Scholar]
- Dooley, I.; Treacy, M.; O’Rourke, M.; Khaild, I.; Kilmartin, D. Serial Spectral Domain Ocular Coherence Tomography Measurement of Outer Nuclear Layer Thickness in Rhegmatogenous Retinal Detachment Repair. Curr. Eye Res. 2015, 40, 1073–1076. [Google Scholar]
- Mete, M.; Maggio, E.; Ramanzini, F.; Guerriero, M.; Airaghi, G.; Pertile, G. Microstructural Macular Changes after Pars Plana Vitrectomy for Primary Rheg-matogenous Retinal Detachment. Ophthalmologica 2021, 244, 551–559. [Google Scholar]
- Yamada, H.; Imai, H.; Tetsumoto, A.; Hayashida, M.; Otsuka, K.; Miki, A.; Nakamura, M. The contribution of the proximity of the retinal detachment to the fovea for post-operative metamorphopsia after 27-gauge pars plana vitrectomy for the primary rhegmatogenous retinal de-tachment. PLoS ONE 2021, 16, e0258775. [Google Scholar]
- Mané, V.; Chehaibou, I.; Lehmann, M.; Philippakis, E.; Rothschild, P.R.; Bousquet, E.; Tadayoni, R. Preoperative Optical Coherence Tomography Findings of Foveal-Splitting Rhegmatogenous Retinal Detachment. Ophthalmologica 2021, 244, 127–132. [Google Scholar]
- Bansal, A.; Lee, W.W.; Felfeli, T.; Muni, R.H. Real-Time In Vivo Assessment of Retinal Reattachment in Humans Using Swept-Source Optical Coherence Tomography. Am. J. Ophthalmol. 2021, 227, 265–274. [Google Scholar]
- Ozsaygili, C.; Bayram, N. Effects of different tamponade materials on macular segmentation after retinal detachment repair. Jpn. J. Ophthalmol. 2021, 65, 227–236. [Google Scholar] [CrossRef]
- Purtskhvanidze, K.; Hillenkamp, J.; Tode, J.; Junge, O.; Hedderich, J.; Roider, J.; Treumer, F. Thinning of Inner Retinal Layers after Vitrectomy with Silicone Oil versus Gas Endotamponade in Eyes with Macula-Off Retinal Detachment. Ophthalmologica 2017, 238, 124–132. [Google Scholar] [PubMed]
- Raczyńska, D.; Mitrosz, K.; Raczyńska, K.; Glasner, L. The Influence of Silicone Oil on the Ganglion Cell Complex After Pars Plana Vitrectomy for Rhegmatogenous Retinal Detachment. Curr. Pharm. Des. 2018, 24, 3476–3493. [Google Scholar] [PubMed]
- Lee, J.; Cho, H.; Kang, M.; Hong, R.; Seong, M.; Shin, Y. Retinal Changes before and after Silicone Oil Removal in Eyes with Rhegmatogenous Retinal Detachment Using Swept-Source Optical Coherence Tomography. J. Clin. Med. 2021, 10, 5436. [Google Scholar] [CrossRef]
- Horozoglu, F.; Sener, H.; Polat, O.A.; Sever, O.; Potoglu, B.; Celik, E.; Turkoglu, E.B.; Evereklioglu, C. Evaluation of long-term outcomes associated with extended heavy-silicone oil use for the treatment of inferior retinal detachment. Sci. Rep. 2022, 12, 11636. [Google Scholar]
- McKay, B.R.; Bansal, A.; Kryshtalskyj, M.; Wong, D.T.; Berger, A.; Muni, R.H. Evaluation of Subretinal fluid Drainage Techniques During Pars Plana Vitrectomy for Primary Rhegmatogenous Retinal Detachment-ELLIPSOID Study. Am. J. Ophthalmol. 2022, 227–237. [Google Scholar]
- Danese, C.; Lanzetta, P. Optical Coherence Tomography Findings in Rhegmatogenous Retinal Detachment: A Systematic Review. J. Clin. Med. 2022, 11, 5819. [Google Scholar] [CrossRef]
- Hong, E.H.; Cho, H.; Kim, D.R.; Kang, M.H.; Shin, Y.U.; Seong, M. Changes in Retinal Vessel and Retinal Layer Thickness After Vitrectomy in Retinal De-tachment via Swept-Source OCT Angiography. Invest. Ophthalmol. Vis. Sci. 2020, 61, 35. [Google Scholar]
- Chatziralli, I.; Theodossiadis, G.; Parikakis, E.; Chatzirallis, A.; Dimitriou, E.; Theodossiadis, P. Inner retinal layers’ alterations and microvasculature changes after vitrectomy for rhegmatogenous retinal detachment. Int. Ophthalmol. 2020, 40, 3349–3356. [Google Scholar]
- Xu, C.; Wu, J.; Feng, C. Changes in the postoperative foveal avascular zone in patients with rhegmatogenous retinal de-tachment associated with choroidal detachment. Int. Ophthalmol. 2020, 40, 2535–2543. [Google Scholar]
- Nam Sang, H.; Kim, K.; Kim Eung, S.; Kim, D.G.; Yu, S.Y. Longitudinal Microvascular Changes on Optical Coherence Tomographic An-gi-ography after Macula-Off Rhegmatogenous Retinal Detachment Repair Surgery. Ophthalmologica 2021, 244, 34–41. [Google Scholar] [PubMed]
- Roohipoor, R.; Tayebi, F.; Riazi-Esfahani, H.; Khodabandeh, A.; Karkhaneh, R.; Davoudi, S.; Khurshid, G.S.; Momenaei, B.; Ebrahimiadib, N.; Modjtahedi, B.S. Optical coherence tomography angiography changes in macula-off rhegmatogenous retinal detachments repaired with silicone oil. Int. Ophthalmol. 2020, 40, 3295–3302. [Google Scholar] [PubMed]
- Reumueller, A.; Wassermann, L.; Salas, M.; Karantonis, M.G.; Sacu, S.; Georgopoulos, M.; Drexler, W.; Pircher, M.; Pollreisz, A.; Schmidt-Erfurth, U. Morphologic and Functional Assessment of Photoreceptors After Macula-Off Retinal Detachment With Adaptive-Optics OCT and Microperimetry. Am. J. Ophthalmol. 2020, 214, 72–85. [Google Scholar]
- Zawadzki, R.J.; Choi, S.S.; Jones, S.M.; Oliver, S.S.; Werner, J.S. Adaptive optics-optical coherence tomography: Optimizing visualization of microscopic retinal structures in three dimensions. J. Opt. Soc. Am. A Opt. Image Sci. Vis. 2007, 24, 1373–1383. [Google Scholar] [PubMed]
- Comet, A.; Ramtohul, P.; Stolowy, N.; Gascon, P.; Denis, D.; David, T. Role of en face OCT in following outer retinal folds after rhegmatogenous retinal detachment. J. Fr. D’ophtalmologie 2021, 44, e479–e481. [Google Scholar]
- Fukuyama, H.; Yagiri, H.; Araki, T.; Iwami, H.; Yoshida, Y.; Ishikawa, H.; Kimura, N.; Kakusho, K.; Okadome, T.; Gomi, F. Quantitative assessment of outer retinal folds on enface optical coherence to-mography after vitrectomy for rhegmatogenous retinal detachment. Sci. Rep. 2019, 9, 2327. [Google Scholar]
- Matoba, R.; Kanzaki, Y.; Doi, S.; Kanzaki, S.; Kimura, S.; Hosokawa, M.M.; Shiode, Y.; Takahashi, K.; Morizane, Y. Assessment of epiretinal membrane formation using en face optical coherence to-mography after rhegmatogenous retinal detachment repair. Graefes Arch. Clin. Exp. Ophthalmol. 2021, 259, 2503–2512. [Google Scholar]
- Fung, T.H.M.; John, N.C.R.A.; Guillemaut, J.Y.; Yorston, D.; Frohlich, D.; Steel, D.H.W.; Williamson, T.H.; BEAVRS Retinal Detachment Outcomes Group. Artificial intelligence using deep learning to predict the anatomical outcome of rhegmatogenous retinal detachment surgery: A pilot study. Graefes Arch. Clin. Exp. Ophthalmol. 2023, 261, 715–721. [Google Scholar]
- Guo, H.; Ou, C.; Wang, G.; Lu, B.; Li, X.; Yang, T.; Zhang, J. Prediction of Visual Outcome After Rhegmatogenous Retinal Detachment Surgery Using Artificial Intelligence Techniques. Transl. Vis. Sci. Technol. 2024, 13, 17. [Google Scholar]
- Ferro Desideri, L.; Danilovska, T.; Bernardi, E.; Artemiev, D.; Paschon, K.; Hayoz, M.; Jungo, A.; Sznitman, R.; Zinkernagel, M.S.; Anguita, R. Artificial Intelligence-Enhanced OCT Biomarkers Analysis in Macula-off Rhegmatogenous Retinal Detachment Patients. Transl. Vis. Sci. Technol. 2024, 13, 21. [Google Scholar]
- Coppola, M.; Marchese, A.; Cicinelli, M.V.; Rabiolo, A.; Giuffrè, C.; Gomarasca, S.; Querques, G.; Bandello, F. Macular optical coherence tomography findings after vitreoretinal surgery for rhegmatogenous retinal detachment. Eur. J. Ophthalmol. 2020, 30, 805–816. [Google Scholar] [CrossRef] [PubMed]
- Fallico, M.; Alosi, P.; Reibaldi, M.; Longo, A.; Bonfiglio, V.; Avitabile, T.; Russo, A. Scleral Buckling: A Review of Clinical Aspects and Current Concepts. J. Clin. Med. 2022, 11, 314. [Google Scholar] [CrossRef] [PubMed]
- Veckeneer, M.; Derycke, L.; Lindstedt, E.W.; van Meurs, J.; Cornelissen, M.; Bracke, M.; Van Aken, E. Persistent subretinal fluid after surgery for rhegmatogenous retinal detachment: Hypothesis and review. Graefes Arch. Clin. Exp. Ophthalmol. 2012, 250, 795–802. [Google Scholar] [CrossRef] [PubMed]
- Baba, T.; Hirose, A.; Moriyama, M.; Mochizuki, M. Tomographic image and visual recovery of acute macula-off rhegmatogenous retinal detachment. Graefes Arch. Clin. Exp. Ophthalmol. 2004, 242, 576–581. [Google Scholar] [CrossRef]
- Seo, J.H.; Woo, S.J.; Park, K.H.; Yu, Y.S.; Chung, H. Influence of persistent submacular fluid on visual outcome after successful scleral buckle surgery for macula-off retinal detachment. Am. J. Ophthalmol. 2008, 145, 915–922. [Google Scholar] [CrossRef]
- Benson, S.E.; Schlottmann, P.G.; Bunce, C.; Xing, W.; Charteris, D.G. Optical coherence tomography analysis of the macula after scleral buckle surgery for retinal detachment. Ophthalmology 2007, 114, 108–112. [Google Scholar] [CrossRef]
- Hagimura, N.; Iida, T.; Suto, K.; Kishi, S. Persistent foveal retinal detachment after successful rhegmatogenous retinal detachment surgery. Am. J. Ophthalmol. 2002, 133, 516–520. [Google Scholar] [CrossRef]
- Fu, Y.; Chen, S.; Gu, Z.H.; Zhang, Y.L.; Li, L.Y.; Yang, N. Natural history of persistent subretinal fluid following the successful repair of rhegmatogenous retinal detachment. Int. J. Ophthalmol. 2020, 13, 1621–1628. [Google Scholar] [CrossRef]
- Kim, J.M.; Lee, E.J.; Cho, G.E.; Bae, K.; Lee, J.Y.; Han, G.; Kang, S.W. Delayed Absorption of Subretinal Fluid after Retinal Reattachment Surgery and Associated Choroidal Features. Korean, J. Ophthalmol. 2017, 31, 402–411. [Google Scholar] [CrossRef]
- Theodossiadis, P.G.; Georgalas, I.G.; Emfietzoglou, J.; Kyriaki, T.E.; Pantelia, E.; Gogas, P.S.; Moschos, M.N.; Theodossiadis, G.P. Optical coherence tomography findings in the macula after treatment of rhegmatogenous retinal detachments with spared macula preoperatively. Retina 2003, 23, 69–75. [Google Scholar] [CrossRef]
- Hänsli, C.; Lavan, S.; Pfister, I.B.; Schild, C.; Garweg, J.G. Outer retinal features in OCT predict visual recovery after primary macula-involving retinal detachment repair. PLoS ONE 2022, 17, e0268028. [Google Scholar] [CrossRef] [PubMed]
- Lai, T.T.; Huang, J.S.; Yeh, P.T. Incidence and risk factors for cystoid macular edema following scleral buckling. Eye 2017, 31, 566–571. [Google Scholar] [PubMed]
- Lamas-Francis, D.; Bande-Rodríguez, M.; Blanco-Teijeiro, M.J. Primary ILM peeling during retinal detachment repair: A systematic review and meta-analysis. Sci. Rep. 2023, 13, 3586. [Google Scholar]
- Zaletel Benda, P.; Vratanar, B.; Petrovski, G.; Gavrić, A.U.; Matović, K.; Gornik, A.; Vergot, K.; Lumi, A.; Lumi, X. Prognostic Factor Analysis of Visual Outcome after Vitrectomy for Rhegmatogenous Retinal Detachment. J. Clin. Med. 2020, 9, 3251. [Google Scholar] [CrossRef]
- Miyake, M.; Nakao, S.Y.; Morino, K.; Yasukura, S.; Mori, Y.; Ishihara, K.; Muraoka, Y.; Miyata, M.; Tamura, H.; Sakamoto, T.; et al. Effect of Duration of Macular Detachment on Visual Prognosis after Surgery for Macula-Off Retinal Detachment: Japan-Retinal Detachment Registry. Ophthalmol. Retina 2023, 7, 375–382. [Google Scholar]

| Biomarker | Description | Prognostic Implication |
|---|---|---|
| Photoreceptor layer integrity (EZ and ELM) | Continuity of the ellipsoid zone (EZ) and external limiting membrane (ELM) indicate preserved photoreceptor structure | Intact layers have been shown to correlate with improved postoperative visual acuity, while disruption predicts poorer outcomes [10,11,12,13,14,15,16,17] |
| Height of retinal detachment (HRD) | Vertical distance between the detached foveal retina and the RPE at the fovea | Greater HRD is associated with worse visual outcomes, although some studies report mixed findings [23,24,25,26,27,28,29,30,31,33] |
| Intraretinal cystic cavities (ICCs) | Well-delineated, hyporeflective spaces found within retinal layers secondary to fluid accumulation | Limited ICCs may have little impact, whereas extensive involvement predicts poorer visual acuity [14,16,23,32,37,38,39,40] |
| Retinal thickness parameters | Measurements of central macular thickness (CMT), outer nuclear layer (ONL) thickness, and photoreceptor segment length | While CMT and ONL findings are variable, longer photoreceptors segments have been linked to improved visual recovery [14,16,17,21,30,37] |
| Outer retinal corrugations (ORCs) | High-frequency undulations in outer retinal layers | The presence of ORCs has been associated with poorer visual prognosis, and may indicate a more severe retinal disruption [42,43,44,45] |
| Outer retinal undulations (ORUs) | Directional changes in the outer retinal contour | More common in subacute detachments, may serve as a marker for detachment duration and potential for reversible damage [17,33] |
| Macular detachment | Involvement of macula in retinal detachment | Macula-off detachment results in worse postoperative outcomes when compared to macula-on cases [17,28,46,47,48] |
Disclaimer/Publisher’s Note: The statements, opinions and data contained in all publications are solely those of the individual author(s) and contributor(s) and not of MDPI and/or the editor(s). MDPI and/or the editor(s) disclaim responsibility for any injury to people or property resulting from any ideas, methods, instructions or products referred to in the content. |
© 2025 by the authors. Licensee MDPI, Basel, Switzerland. This article is an open access article distributed under the terms and conditions of the Creative Commons Attribution (CC BY) license (https://creativecommons.org/licenses/by/4.0/).
Share and Cite
Zaidi, H.; Sridhar, J. Optical Coherence Tomography in Retinal Detachment: Prognostic Biomarkers, Surgical Planning, and Postoperative Monitoring. Diagnostics 2025, 15, 871. https://doi.org/10.3390/diagnostics15070871
Zaidi H, Sridhar J. Optical Coherence Tomography in Retinal Detachment: Prognostic Biomarkers, Surgical Planning, and Postoperative Monitoring. Diagnostics. 2025; 15(7):871. https://doi.org/10.3390/diagnostics15070871
Chicago/Turabian StyleZaidi, Humza, and Jayanth Sridhar. 2025. "Optical Coherence Tomography in Retinal Detachment: Prognostic Biomarkers, Surgical Planning, and Postoperative Monitoring" Diagnostics 15, no. 7: 871. https://doi.org/10.3390/diagnostics15070871
APA StyleZaidi, H., & Sridhar, J. (2025). Optical Coherence Tomography in Retinal Detachment: Prognostic Biomarkers, Surgical Planning, and Postoperative Monitoring. Diagnostics, 15(7), 871. https://doi.org/10.3390/diagnostics15070871
